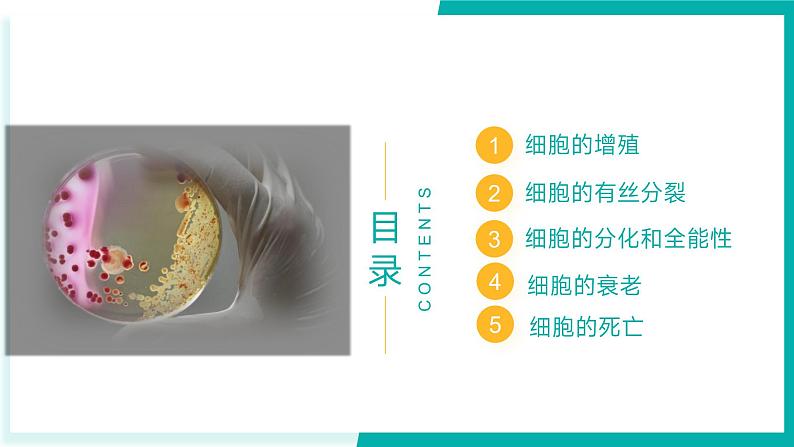
专题五 细胞的生命历程（期末考点串讲）-2023-2024学年高二生物下学期期末考点大串讲（人教版2019）课件PPT02

专题五 细胞的生命历程(期末考点串讲)-2023-2024学年高二生物下学期期末考点大串讲(人教版2019)课件PPT
展开细胞通过细胞分裂增加细胞数量的过程,叫作细胞增殖。
细胞增殖是重要的生命活动,是生物生长、发育、繁殖、遗传的基础。
物质准备—细胞分裂—物质准备—细胞分裂······
细胞增殖包括____________和____________ 两个连续的过程
连续分裂的细胞,从一次分裂完成时开始,到下一次分裂完成时为止,为一个细胞周期。
温馨提示:①“连续分裂的细胞”才具有细胞周期;②间期在前,分裂期在后;③间期长,分裂期短;④以分裂完成时为“界限”。
3.不同细胞的细胞周期持续时间:
(1)细胞周期分为分裂间期和分裂期,分裂间期较长。
(2)不同细胞的细胞周期长度不一样。
(3)不同细胞周期的分裂期或分裂间期占比重不一样。
4.细胞周期的表示方法:
A → B、C → D、E → F
A → C、C → E、 E → G .
B → C、D → E、F → G
【典例01】细胞是一个有机体,会经历增殖、衰老、死亡等生命历程。下列有关细胞生命历程的叙述,正确的是( )
A.有丝分裂前的间期,细胞表面积与体积之比增大B.细胞衰老过程中,细胞中存在活性升高的酶C.细胞增殖和分化均会导致细胞数量增多D.细胞感染病毒后再被清除属于细胞坏死
解析:A、有丝分裂前的间期,细胞体积会增大,即表面积与体积之比减小,A错误;B、细胞衰老过程中,有些与细胞衰老、水解凋亡有关的酶的活性会升高,B正确;C、细胞分化不会导致细胞数目增多,种类会增多,C错误;D、细胞感染病毒后再被清除属于细胞凋亡,D错误。
【典例02】下列对细胞分裂相关知识的叙述正确的是( )
A.多细胞生物体都进行有丝分裂,单细胞生物体都进行无丝分裂B.随着细胞体积增加,其相对表面积增大,运输物质效率明显升高C.有丝分裂过程中染色体及纺锤体周期性出现有利于遗传物质的平均分配D.所有生物细胞分裂完成产生的子细胞都有部分失去分裂能力而进行分化
解析:A、原核生物(如大肠杆菌)以二分裂进行细胞增殖,多细胞生物不都只进行有丝分裂,也可进行无丝分裂(如蛙的红细胞)和减数分裂,A错误;B、随着细胞体积增加,其相对表面积变小,运输物质效率降低,B错误;C、有丝分裂过程中染色体及纺锤体周期性出现有利于遗传物质的平均分配,C正确;D、细胞分裂后产生的子细胞存在三种可能:失去分裂能力成为高度分化的成熟细胞;暂时失去分裂能力;继续保持分裂能力,D错误。
【演练01】下列关于“细胞大小与物质运输的关系”实验的叙述,不正确的是( )
A.该模拟实验中,NaOH扩散的深度不同可以表示细胞的物质运输效率不同B.实验结果表明每一块琼脂小块上NaOH扩散的速率相同C.细胞的表面积与体积之比越大,物质运输效率越高D.实验所用的琼脂小块上含有酚酞,NaOH和酚酞相遇,呈紫红色
【演练02】神经干细胞(NSC)在适当条件下可分化成神经元、少突胶质细胞和星形细胞。图是NSC进入或解除停滞期(暂不增殖的状态)的机制,其中Trbl、Akt、dILPs都是核基因表达的蛋白质。下列叙述正确的是( )
A.NSC属于成体干细胞,其分化成星形细胞时有新基因的产生和表达B.dILPs可通过信号传导激活细胞内的Akt,从而抑制Trbl的作用C.推测Trbl可能通过抑制纺锤体的形成来抑制细胞分裂,使NSC进入停滞期D.Akt相关基因可通过边转录边翻译来实现高效表达,从而促进NSC脱离停滞期进行细胞分裂
G1: 的合成,为 做准备S: 。G2:DNA复制结束,为 做准备, 合成有关的 。
考点02 细胞的有丝分裂
DNA、染色质和染色体的关系:
有丝分裂是一个连续的过程,人们根据染色体的行为,把它分为四个时期:前期、中期、后期、末期。
特征:①核膜核仁消失 ②出现染色体、纺锤体 ③染色体散乱排列
膜仁消失现两体(两消两现)
数量变化:染色体数:2N DNA数: 4N 染色单体数: 4N
特征:①染色体的着丝粒排列在赤道板上 ②染色体形态固定,数目清晰
(是染色体观察及计数的最佳时机)
特征:①着丝粒一分为二,姐妹染色单体分离,变为两个染色体,染色体数目加倍。②形成两套相同的染色体,分别往两极移动
数量变化:染色体数:2N→4N DNA数: 4N 染色单体数: 4N→0
特征:①“两消失”(染色体,纺锤体)②“两出现”(核膜,核仁);③“一重建”赤道板位置出现细胞板形成新的细胞壁,细胞分裂成子细胞。
数量变化:染色体数:4N→2N DNA数: 4N→2N 染色单体数: 0
前期:中心粒发出星射线形成纺锤体
间期:构成中心体的一对中心粒在间期倍增,成为两组。
末期:分裂末期不形成细胞板,而是细胞膜从细胞中部向内凹陷,将细胞缢裂成两部分。
细胞两极发出纺锤丝,形成纺锤体
由两组中心粒周围发出星射线,形成纺锤体
赤道板位置出现细胞板,向四周扩展形成细胞壁
细胞膜内陷,细胞缢裂成两个子细胞
末期是最根本的区别(因为低等植物有中心体)
四、有丝分裂中的相关数量变化
末期结束,细胞一分为二
G1 子细胞
(2)特点:分裂过程中不会出现 的变化。
(3)实例: 的无丝分裂。
六、观察根尖分生组织细胞的有丝分裂
染色体容易被碱性染料染色
如甲紫溶液旧称龙胆紫溶液,或者醋酸洋红液着色。
切取洋葱根尖2~3mm
上午10时-下午2时,剪取2-3mm长的洋葱或大蒜根尖,放入解离液中3-5min
①上午10时-下午2时:分生区细胞分裂旺盛,分裂期细胞较多。
②解离液:质量分数15%盐酸+体积分数95%酒精(1:1混合)
用药液使组织中细胞相互分离开来。
①过长:染色体易破坏;过短:解离不充分。
②解离时细胞已被杀死并固定。
根尖酥软后,放入盛有清水的培养皿10min。洗去材料中残余的解离液,防止解离过度,便于染色。
注意:漂洗彻底。①防止残留的解离液继续破坏细胞;②盐酸会影响染色效果。
甲紫溶液(醋酸洋红液)3-5min,使染色体着色
注意:染色时间太短:染色体或染色质不能完全着色;过长:使其他部分也被染成深色,无法分辨染色体
①载玻片中央滴一滴清水;②镊子把根尖弄碎,盖上盖玻片;③并用手指轻轻按压。使细胞分散开,便于观察。
注意:压片用力必须恰当。过重:将组织压烂;过轻:细胞未分散开
【典例01】真核细胞分裂间期,染色体完成复制后产生的姐妹染色单体保持相互黏附状态,在分裂期才会分离并平均分配到子细胞中。黏连蛋白(姐妹染色单体之间的连结蛋白)的裂解是分离姐妹染色单体的关键性事件,分离酶(SEP)是水解黏连蛋白的关键酶,它的活性被严密调控(APC,SCR是与SEP活性密切相关的蛋白质)。下图(a)(b)(c)分别表示分裂过程中细胞内发生的变化以及对应细胞内某些化合物的含量变化。下列说法错误的是( )
A.a时期,SCR能与SEP紧密结合,阻止SEP水解黏连蛋白B.b时期,APC含量上升,使SCR分解C.若在细胞分裂时秋水仙素处理,最可能会抑制APC的活性D.若APC的活性被抑制,姐妹染色单体就难以分离
解析:A、据图可知,a时期,SCR能与SEP紧密结合,SEP活性低,阻止SEP水解黏连蛋白,A正确;B、b时期,APC含量上升,APC与SCR结合,使SCR分解,B正确;C、秋水仙素会抑制纺锤体的形成,而姐妹染色单体正常分离,不会抑制APC的活性,C错误;D、若APC的活性被抑制,则不能使SCR分解,SCR仍与SEP紧密结合,SEP活性低,阻止SEP水解黏连蛋白,姐妹染色单体就难以分离,D正确。
【典例02】图1为某二倍体(2N=8)生物细胞分裂时细胞中部分常染色体的模式图,图2为细胞分裂过程中同源染色体对数的变化。下列相关分析正确的是( )
A.图1细胞中核DNA的复制时期对应于图2中的AB、FG段B.若不考虑基因突变,则①②上DNA分子的碱基序列完全相同C.图1细胞是图 2中DE段变化的结果,该变化导致子细胞中染色体数减半D.图1细胞中①②分开发生在图2的HI段,①②分开时的细胞中有8条染色体
解析:A、分析题图可知,图1细胞处于减数分裂Ⅱ中期,图1细胞中核DNA的复制时期,即减数分裂前的间期发生在FG段,A错误;B、减数分裂Ⅰ前期,同源染色体的非姐妹染色单体可能会发生互换,导致①②上DNA分子的碱基序列不完全相同,B错误;C、图1细胞是图 2中GH段变化的结果,该变化导致子细胞中染色体数减半,C错误;D、图1细胞中①②分开发生减数分裂Ⅱ后期,即图2的HI段,①②分开时的细胞中有8条染色体,D正确。
【典例03】有丝分裂中期染色体的着丝粒只与一侧的纺锤丝相连,细胞将延缓后期的起始,直至该染色体与另一极的纺锤丝相连,并正确排列在赤道板上。此过程受位于染色体上的 Mad2 蛋白的控制,其机制是 Mad2 蛋白提供一个“等待”信号延缓后期的起始,直到所有染色体着丝粒正确排列在赤道板上该蛋白才会消失。下列叙述正确的是( )
A.Mad2 蛋白含量在有丝分裂时呈周期性变化B.Mad2 蛋白异常会导致细胞分裂过程中出现单附着染色体C.若分裂中的细胞出现单附着染色体,则其子代细胞发生染色体变异D.秋水仙素处理使细胞染色体数目加倍的原因是破坏了 Mad2 蛋白
解析:A、Mad2 蛋白提供一个“等待”信号延缓后期的起始,直到所有染色体着丝粒正确排列在赤道板上该蛋白才会消失,说明Mad2 蛋白在有丝分裂过程中会周期性的出现和消失,A正确;BC、“有丝分裂中期染色体的着丝粒只与一侧的纺锤丝相连,细胞将延缓后期的起始,直至该染色体与另一极的纺锤丝相连,并正确排列在赤道板上”说明正常分裂的细胞也可能有一阶段出现单附着染色体,BC错误;D、秋水仙素处理使得细胞染色体数目加倍的原因是抑制纺锤体的形成,D错误。
【演练01】图甲表示洋葱根尖的不同区域,图乙为高倍显微镜下观察到的洋葱根尖分生区细胞有丝分裂图像。下列说法正确的是( )
A.实验过程中需对根尖先后进行解离、染色、漂洗,再制成临时装片显微观察B.图甲3区细胞生长较快,是观察有丝分裂最佳区域,且最好选择上午10时至下午2时的根尖进行制片观察C.若将显微镜倍数继续放大,可看到视野中多个细胞存在线粒体和叶绿体D.实验过程中,持续观察可看到D细胞中核仁逐渐解体,核膜逐渐消失的动态变化
【演练02】染色体核型分析是根据染色体的长度、着丝粒位置、长短臂比例等特征,借助显带技术对染色体进行分析、比较、排序和编号,根据染色体结构和数目的变异情况来进行诊断的技术。进行核型分析时,一般会用到低渗溶液、秋水仙素、卡诺氏液等。下列叙述正确的是( )
A.染色体核型分析一般选择分裂中期的染色体为研究对象,用甲紫等酸性染料染色B.低渗溶液可使细胞吸水膨胀,便于制片时细胞破裂,释放出染色体C.秋水仙素的本质是吲哚乙酸,属于酸性溶液,高浓度可抑制纺锤体形成D.卡诺氏液能很好的固定并维持染色体结构的完整性,使染色体着丝粒整齐排列在赤道板上
【演练03】某兴趣小组将培养获得的二倍体和四倍体洋葱根尖,分别制作有丝分裂的临时装片进行观察。下图为二倍体洋葱根尖细胞的照片。下列叙述,正确的是( )
A.植物细胞有丝分裂临时装片的制作步骤为解离—染色—漂洗—制片B.细胞②处于有丝分裂前的分裂间期,视野中细胞②的数量比①、③多C.处于①状态的细胞完成分裂后,细胞内染色体数目是体细胞的一半D.四倍体洋葱处于有丝分裂中期的细胞中染色体数是②、③的4倍
【演练04】一些细胞可以暂时脱离细胞周期暂不分裂增殖,但在适当情况下又可重新进入细胞周期,这样的细胞称为G0期细胞(G0期和一个细胞周期如图所示)。下列关于G0期细胞叙述错误的是( )(注:G1期为DNA复制前的间期、S期为DNA复制时期、G2期为DNA复制后的间期、M期为分裂期)
A.G0期种子细胞中的自由水与结合水的比值往往比M期细胞的低B.G0期细胞核DNA数量是G2期细胞的2倍,而染色体数目相等C.G0期记忆细胞再次接触相同抗原会重返细胞周期,参与二次免疫D.G0期细胞癌变后会重新进入细胞周期,但比原正常细胞的周期短
考点03 细胞的分化和全能性
在个体发育中,由一个或一种细胞增殖产生的后代,在形态、结构和生理功能上发生稳定性差异的过程。
产生形态、结构、功能不同的细胞。
a.是个体发育的基础。b.使多细胞生物体中的细胞趋于专门化,有利于提高各种生理功能的效率。
细胞经分裂和分化后,仍具有产生完整有机体或分化成其他各种细胞的潜能和特性。
体细胞内含有生物生长发育所需的全套遗传物质
受精卵 > 生殖细胞 > 体细胞
01. 快速繁殖花卉、蔬菜等
02. 拯救珍稀、濒危动植物
03. 克隆人体器官,用于器官移植
①持久性 ②稳定性③不可逆性 ④普遍性
①高度分化的植物体细胞具有全能性;②动物细胞核仍具有全能性
含有本物种全套遗传物质
细胞分化程度有高低之分:体细胞>生殖细胞>受精卵
细胞全能性有高低之分:受精卵>生殖细胞>体细胞
形成形态、结构、功能不同的细胞或器官
完整有机体或分化成其他各种细胞
②一般来说,细胞分化程度越高,全能性越难以表达,细胞分化程度越低,全能性就越高(成反比)
①细胞分化不会导致遗传物质改变,已分化的细胞都含有保持本物种遗传特性所需要的全套遗传物质,因而都具有全能性;
【典例01】某种水母的触手断掉后能在两到三天内再生。研究发现,水母中一种积极生长和分裂的干细胞样增殖细胞,出现在了受伤部位并能帮助形成新的触手。下列关于干细胞样增殖细胞的叙述正确的是( )
A.干细胞样增殖细胞具有细胞周期B.干细胞样增殖细胞与再生触手细胞的核遗传物质不同C.干细胞样增殖细胞再生成触手的过程体现其有全能性D.干细胞样增殖细胞是一种不会凋亡的细胞
解析:A、干细胞样增殖细胞是连续分裂的细胞,具有细胞周期,A正确;B、同一生物细胞的遗传物质都源于受精卵,其遗传物质相同,B错误;C、干细胞样增殖细胞再生成触手(未形成完整个体)的过程,不能体现其有全能性,C错误;D、干细胞样增殖细胞也会发生凋亡,D错误。
【典例02】植物通过产生愈伤组织进而分化来实现再生,动物也会发生类似的过程。特定细胞的分化需要相应的调控蛋白才能启动,多细胞生物体内的调控蛋白的种类通常远少于细胞种类。下列叙述错误的是( )
A.细胞、组织、器官的再生体现了细胞的全能性B.动物组织、器官的再生需要经过类似脱分化的过程C.调控蛋白启动特定细胞的分化体现了基因的选择性表达D.一种调控蛋白可能参与多种类型细胞的形成
解析:A、细胞全能性是发育为完整个体或分化为各种细胞,细胞、组织、器官的再生没有上述结果,不能体现全能性,A错误;B、动物组织、器官的再生需要经过类似脱分化的过程,使其成为未分化状态,B正确;C、细胞分化的实质是基因的选择性表达,调控蛋白启动特定细胞的分化体现了基因的选择性表达,C正确;D、分析题意可知,多细胞生物体内的调控蛋白的种类通常远少于细胞种类,据此推测一种调控蛋白可能参与多种类型细胞的形成,D正确。
【演练01】我国科学家将体细胞移植到去核的卵细胞中,成功培育出世界上首例体细胞克隆猴“中中” 和“华华”。下列关于细胞的叙述正确的是( )
A.克隆猴体细胞中核酸种类相同B.克隆猴体内衰老细胞中所有酶的活性均降低C.克隆猴体内细胞坏死是由遗传机制决定的程序性死亡D.克隆猴的成功培育说明已分化的动物细胞核具有全能性
【演练02】如图表示造血干细胞的生长、增殖和分化的过程,下列相关叙述不正确的是( )
A.过程①细胞a体积增大,物质运输效率下降B.造血干细胞形成各种血细胞的过程体现了细胞的全能性C.干细胞分化成成熟红细胞的过程中,细胞器的种类、数量会发生变化D.白细胞所含的遗传信息与造血干细胞相同
细胞的生理状态和化学反应发生复杂变化的过程,其在形态、结构、功能上都发生明显的变化。
①细胞膜通透性改变,使物质运输功能降低
②细胞核的体积增大,核膜内折,染色质收缩、染色加深
③细胞内的水分减少,细胞萎缩,体积变小
④细胞内多种酶的活性降低,呼吸速率减慢,新陈代谢速率减慢
⑤细胞内的色素逐渐积累,妨碍细胞内物质的交流和传递
体积变小
体积增大
细胞内 减少
细胞内 逐渐积累增多
细胞的 减慢; 减慢
细胞内 活性降低;细胞 功能降低
收缩
内折
改变
(1)自由基学说自由基本质:异常活泼的 。
(2)端粒学说①端粒:一段特殊序列的 复合体。②端粒位置: 两端。
4.细胞衰老与个体衰老的关系:
细胞衰老或死亡 ≠ 个体衰老或死亡
细胞衰老或死亡 = 个体衰老或死亡
个体衰老是组成个体的细胞普遍衰老的过程
细胞衰老是人体内发生的正常生命现象
正常的细胞衰老有利于机体更好地实现自我更新。
众多细胞的衰老会导致人体的衰老
出现免疫力下降、适应环境能力减弱等现象。
【典例01】图为三种诱发细胞衰老的机制,下列有关细胞衰老的说法错误的是( )
A.细胞周期阻滞是导致细胞衰老的关键环节B.细胞端粒的延长或缩短都会加速细胞衰老C. 等酶的磷酸化可能会引起细胞衰老D.衰老细胞的 会有不同程度的损伤
解析:A、三种方式都会引发细胞周期阻滞,进而产生衰老特征引起衰老,A正确;B、端粒缩短会加速衰老,延长可以延缓衰老,B错误;C、激活损伤反应会引起等酶的磷酸化,进而引发衰老,C正确;D、细胞衰老之前都会出现损伤或者损伤反应,D正确。
【典例02】线粒体正常的形态和数量与其融合、裂变相关,该过程受DRP-1和FZ0-1等基因的调控。衰老过程中,肌肉细胞线粒体形态数量发生变化、线粒体碎片化增加。下图是研究运动对衰老线虫肌肉细胞线粒体影响的结果。下列叙述正确的是( )注:颜色越深代表细胞中线粒体碎片化程度越高;drp-1、fz-1代表相关突变体。
A.线粒体是细胞合成ATP的唯一场所B.运动可减缓衰老引起的线粒体碎片化C.敲除基因一定会加重线粒体碎片化D.线粒体融合与裂变对细胞完成正常生命活动是有害的
解析:A、除了线粒体可以产生ATP外,线虫肌肉细胞中细胞质基质也可以产生ATP,A错误;B、根据图示信息,颜色越深代表细胞中线粒体碎片化程度越高,无论是10日龄,还是5日龄,运动组与对照组相比较,线粒体的碎片化细胞比例均降低,说明运动可减缓衰老引起的线粒体碎片化,B正确;C、依据图示信息,DRP-1基因突变体,与野生型相比较,线粒体碎片化细胞比例上升,说明DRP-1基因突变会加重线粒体碎片化,但并不能得出敲除DRP-1基因会加重线粒体碎片化的结论,C错误;D、由野生型实验可以看出,无论是10日龄,还是5日龄,运动组与对照组相比较,线粒体的碎片化细胞比例均降低,说明运动可减缓衰老引起的线粒体碎片化,但是线粒体融合与裂变是否为运动益处所必需,无法判断,D错误。
【演练01】在人体生命活动中,细胞不断进行各种氧化反应,很容易产生异常活泼的带电分子或基团。自由基攻击和破坏细胞内各种执行正常功能的生物分子,致使细胞衰老。下列有关说法正确的是( )
A.若自由基攻击细胞膜上的受体分子,不会影响细胞间的信息交流B.若自由基攻击细胞膜中的DNA分子,可能会引起基因碱基序列的改变C.若自由基攻击磷脂分子,可能影响葡萄糖进入线粒体氧化分解D.人体细胞若能及时清除自由基,可能延缓细胞衰老
【演练02】研究发现细胞衰老与其线粒体损伤有关。线粒体损伤后功能出现障碍,进而导致活性氧( ROS)类代谢紊乱,ROS过多会使蛋白质的功能发生改变。下列相关叙述错误的是( )
A.ROS可能使蛋白质的空间结构发生改变B.提高溶酶体中酶的活性可以延缓细胞衰老C.线粒体的衰老是一种正常的生命现象D.线粒体受损后,其分解葡萄糖的速率下降
细胞死亡包括凋亡和坏死等方式,其中凋亡是细胞死亡的一种主要方式。
由基因所决定的细胞自动结束生命的过程,就叫细胞凋亡。
与凋亡相关的基因选择性表达的结果。
指在种种不利因素影响下,如极端的物理、化学因素或严重的病理性刺激的情况下,由于细胞的正常代谢活动受损或中断,从而引起细胞的损伤和死亡。
坏死细胞的膜通透性增高,致使细胞肿胀,细胞器变形或肿大,最后细胞破裂。
对机体是有利,不发生炎症
对机体是有害,发生炎症
通俗地说,就是吃掉自身的结构和物质。在一定条件下,细胞会将受损或功能退化的细胞结构等,通过溶酶体降解后再利用。
获得维持生存所需的物质和能量;清除受损或衰老的细胞器,及感染的微生物和毒素,维持细胞内部环境的稳定。
有些激烈的细胞自噬,可能诱导细胞凋亡
【典例01】肿瘤细胞能被免疫系统识别和清除。T淋巴细胞针对肿瘤细胞发生免疫应答的部分过程如图所示。下列叙述正确的是( )
A.T淋巴细胞活化增殖为细胞a后,细胞a的遗传物质会发生改变B.T淋巴细胞活化增殖为细胞a时,还会产生记忆T细胞C.免疫系统识别和清除肿瘤细胞的过程体现了免疫防御功能D.图中肿瘤细胞的死亡属于细胞坏死,是由基因所决定的程序性死亡
解析:AB、T淋巴细胞活化增殖为细胞a细胞毒性T细胞和记忆T细胞,细胞a的遗传物质不会发生改变,A错误,B正确;C、免疫系统识别和清除肿瘤细胞的过程体现了免疫监视功能,C错误;D、图中肿瘤细胞的死亡属于细胞凋亡,是由基因所决定的程序性死亡,D错误。
【典例02】“分子伴侣”是一大类蛋白质的统称,它们通过改变自身空间结构与多肽的某些部位相结合,从而介导其他蛋白质的正确装配,但其本身不参与组成最终产物并可循环发挥作用。后来科学家发现某真核生物的A基因可以编码一种分子伴侣A,分子伴侣A可介导细胞自噬,进一步研究发现癌细胞和冬眠时的哺乳动物细胞中分子伴侣A明显增多。下列叙述正确的是( )
A.通道蛋白、载体蛋白在发挥作用时与“分子伴侣”类似,也需要改变自身空间结构并与运输的物质结合B.分子伴侣和胰岛素发挥作用后的去向相同C.RNA聚合酶通过碱基互补配对识别A基因的启动子并与之结合,启动A基因的转录D.动物冬眠时,分子伴侣A介导的自噬可为细胞提供营养
解析:A、通道蛋白在发挥作用时不需要与运输的物质结合,A错误;B、分子伴侣可循环发挥作用,胰岛素发挥作用后会被灭活,B错误;C、RNA聚合酶本质是蛋白质,组成上不存在碱基,无法通过碱基互补配对识别启动子,C错误;D、分子伴侣A介导的自噬将细胞中的一些蛋白质降解,从而为细胞生命活动提供营养物质,D正确。
【演练01】溶酶体所含的水解酶是由附着型核糖体合成的。当细胞处于“饥饿”状态时, 溶酶体吞噬消化分解一部分细胞器来获取能量,该现象为细胞自噬;休克时,机体细胞溶酶体内的酶向组织内外释放,多在肝和肠系膜等处,引起细胞和组织自溶。下列说法正确的是( )
A.休克时,测定血液中溶酶体水解酶的含量高低,可作为细胞损伤轻重程度的定量指标B.溶酶体是高尔基体出芽形成的,其膜蛋白的含量和种类与高尔基体膜的相同C.细胞自噬后的产物均以代谢废物的形式排出细胞外D.自噬体和溶酶体的融合说明了生物膜在功能上具有一定的流动性
【演练02】研究表明,自噬—溶酶体途径参与胶质母细胞瘤(GBM)的发生。调节蛋白3(Sirt3)在GBM患者体内的表达水平较高,敲除Sirt3基因会导致溶酶体膜蛋白LAMP2A表达显著减少。正常情况下,细胞内的溶酶体数目处于动态平衡,溶酶体数目异常可能会导致细胞清除能力产生障碍,诱发细胞凋亡。下列说法错误的是( )
A.溶酶体能分解衰老、损伤的细胞器或功能退化的细胞结构B.敲除Sirt3基因可能会诱导GBM细胞发生凋亡C.使用溶酶体膜蛋白LAMP2A激活剂可能有助于GBM的治疗D.自噬降解产物可被再利用,获得维持细胞生存所需的物质和能量
专题四 细胞的代谢(期末考点串讲)-2023-2024学年高二生物下学期期末考点大串讲(人教版2019)课件PPT: 这是一份专题四 细胞的代谢(期末考点串讲)-2023-2024学年高二生物下学期期末考点大串讲(人教版2019)课件PPT,共60页。PPT课件主要包含了光合作用,细胞的物质输入和输出,酶与ATP,细胞呼吸,思维导图,物质跨膜运输的实例,考点01,渗透作用,渗透系统变式分析,水进出细胞的原理等内容,欢迎下载使用。
专题二 细胞工程与胚胎工程(期末考点串讲)-2023-2024学年高二生物下学期期末考点大串讲(人教版2019)课件PPT: 这是一份专题二 细胞工程与胚胎工程(期末考点串讲)-2023-2024学年高二生物下学期期末考点大串讲(人教版2019)课件PPT,共60页。PPT课件主要包含了胚胎工程的应用,体内受精和胚胎发育,思维导图,植物细胞工程,考点01,考点02,考点03,考点04,考点05,考点06等内容,欢迎下载使用。
专题一 发酵工程与基因工程(期末考点串讲)-2023-2024学年高二生物下学期期末考点大串讲(人教版2019)课件PPT: 这是一份专题一 发酵工程与基因工程(期末考点串讲)-2023-2024学年高二生物下学期期末考点大串讲(人教版2019)课件PPT,共60页。PPT课件主要包含了基因工程的应用,微生物的培养及应用,酶的研究与应用,基因工程的基本工具,蛋白质工程,思维导图,传统发酵技术的应用,考点01,果酒果醋的制作,腐乳的制作等内容,欢迎下载使用。












